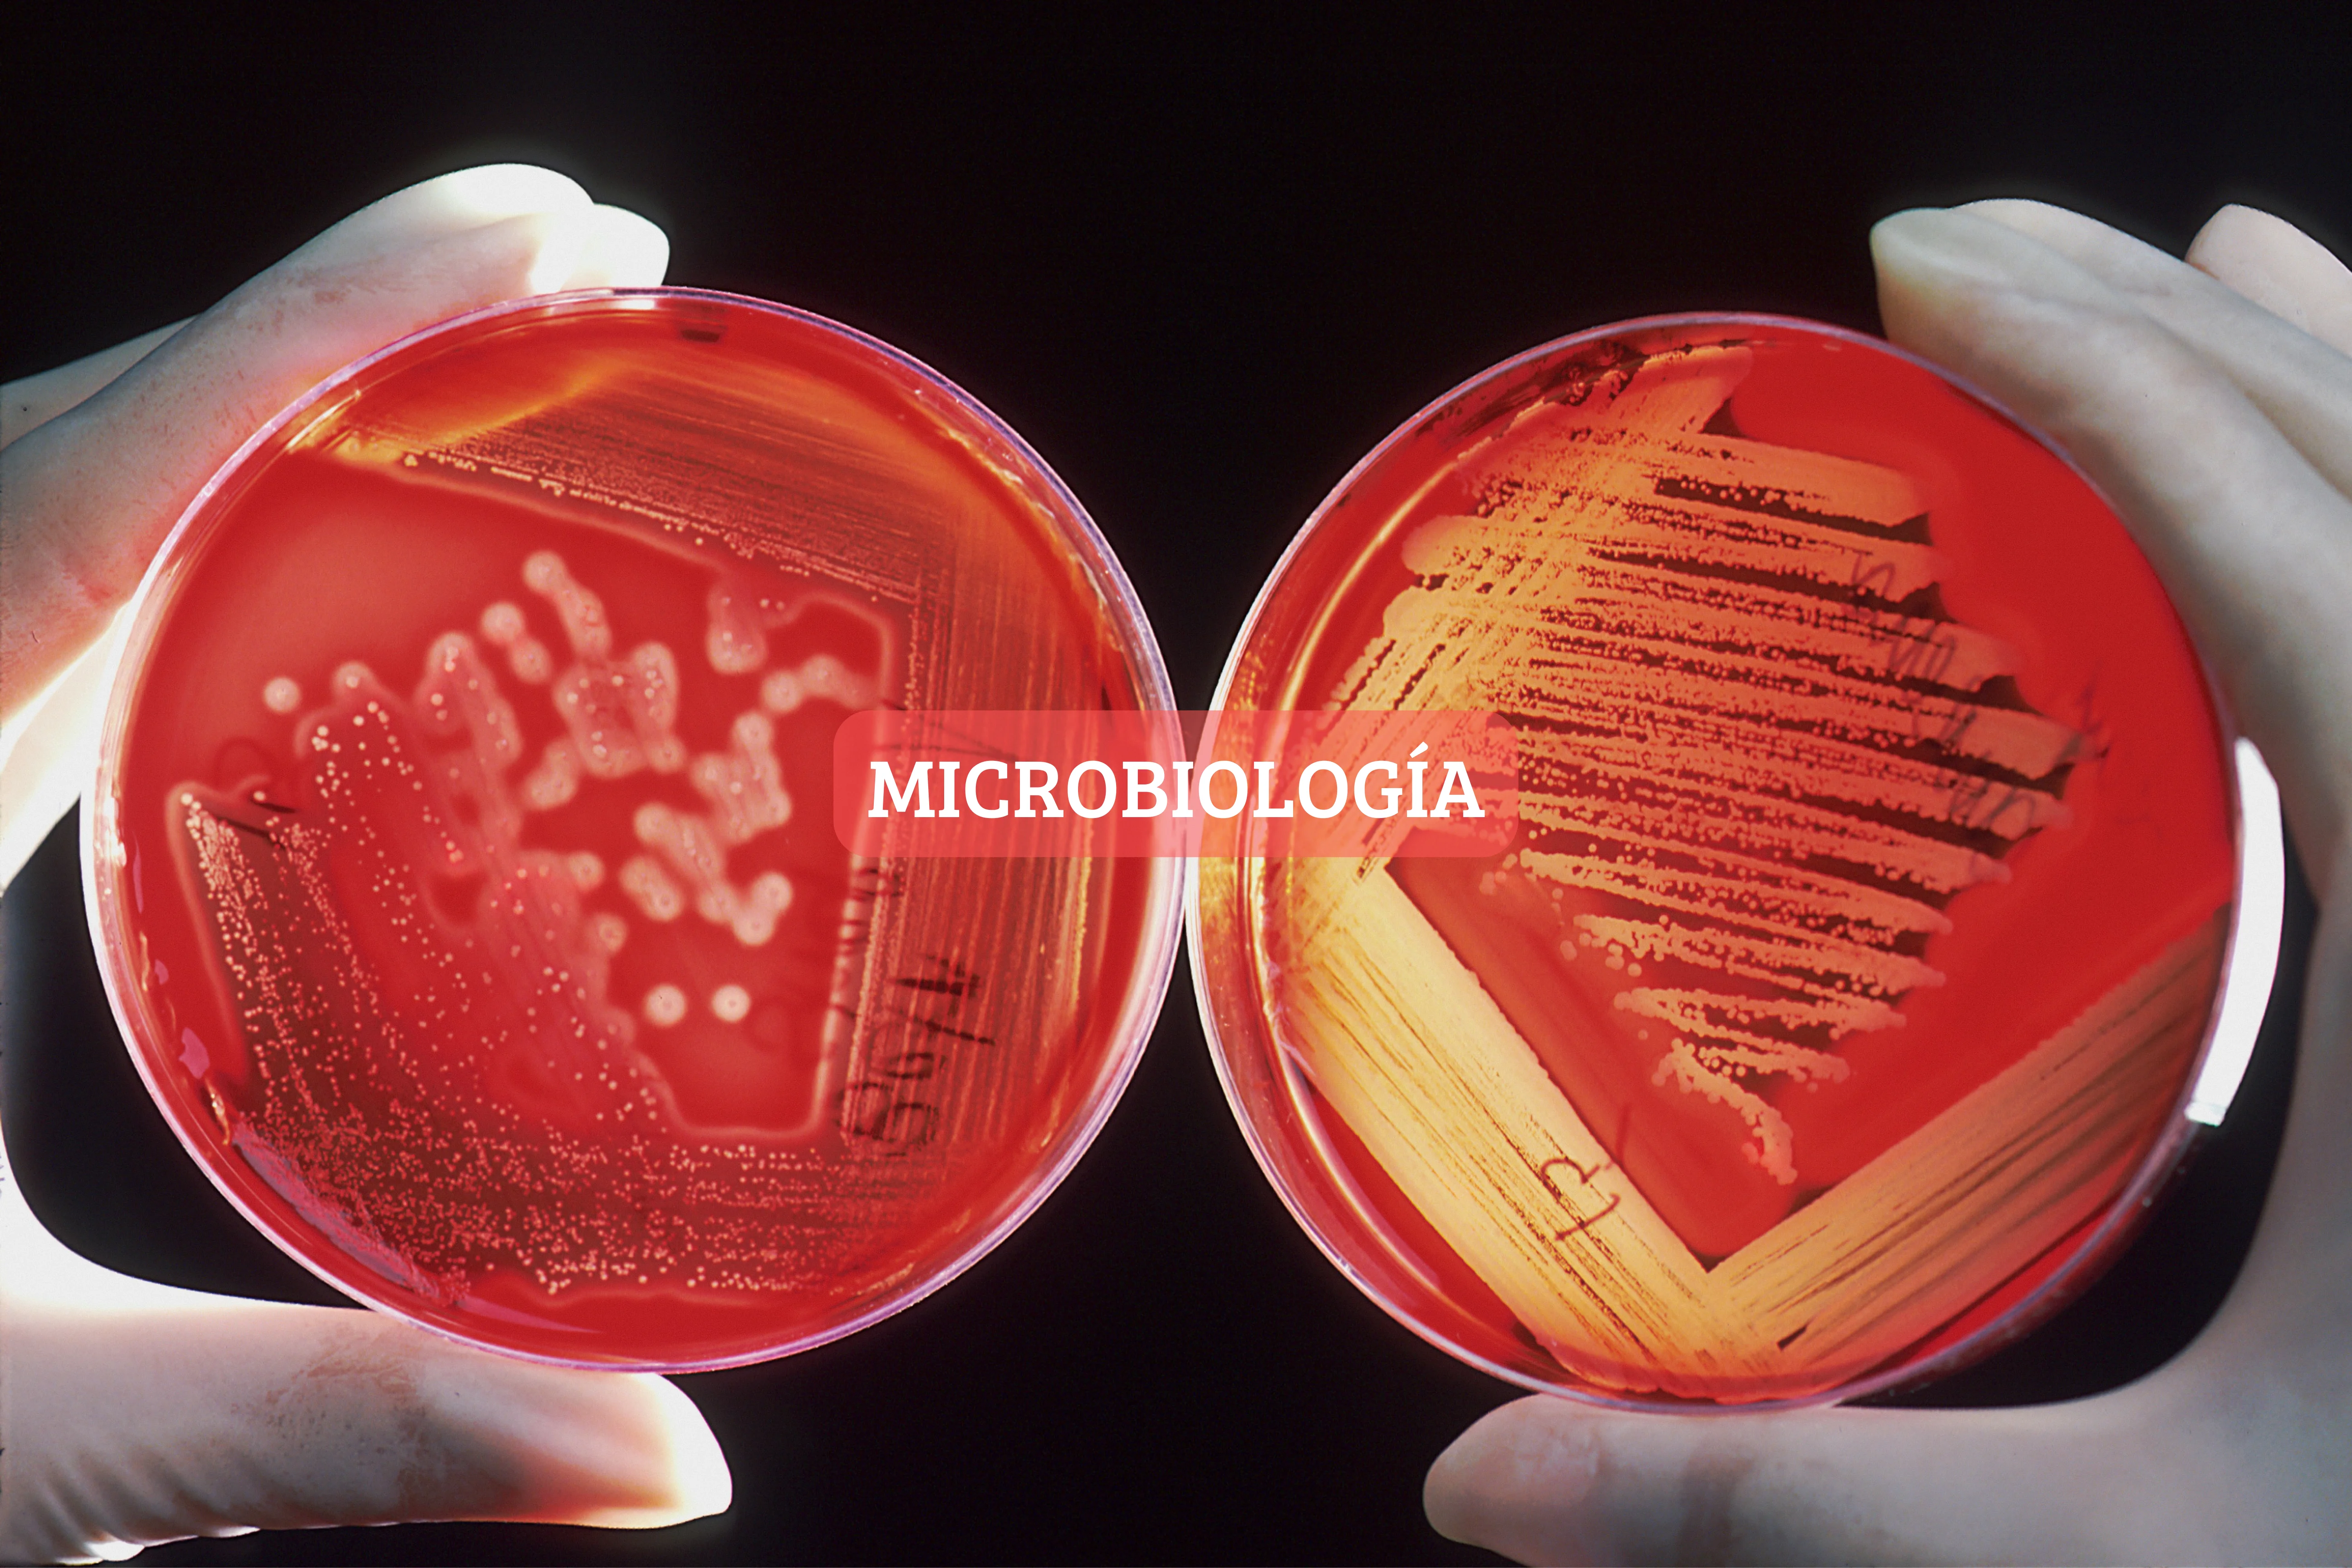

Nuestro personal técnico es capacitado constantemente y cuenta con certificados que avalan su competencia técnica. Nuestros clientes reciben atención personalizada y de manera directa por el personal técnico, para la resolución de dudas y problemas.

Nuestros informes técnicos incluyen evidencia documentada y verificada, que aseguran confiabilidad de cada una de las mediciones realizadas durante el servicio. Todos los patrones de referencia utilizados son calibrados a intervalos definidos, con proveedores acreditados, asegurando la trazabilidad de las mediciones.

El personal técnico cuenta con el equipo de seguridad necesario para la realización de servicios en las instalaciones de nuestros clientes: Bata de laboratorio, Lentes de seguridad, Casco, Zapatos de seguridad, Guantes Además de que nuestros colaboradores tienen capacitación con base en la NOM-035-STPS.

Nuestro personal técnico realiza los servicios en sitio, el cliente no se debe preocupar por enviar y recolectar su equipo o instrumento. Brindamos servicios en toda la República Mexicana, Centroamérica y Sudamérica.

Conoce la amplia gama de equipos a los que les brindamos servicio. Visita nuestra sección de Servicios o contáctanos.

Consulta nuestra sección de ventas o contáctanos para brindarte una atención personalizada.
Ciencia de las mediciones y sus aplicaciones.
La metrología incluye todos los aspectos teóricos y prácticos de las
mediciones, cualesquiera que sean su incertidumbre de medida y su campo de aplicación.
El mantenimiento a equipos pretende mantenerlos en las mejores condiciones que permita prolongar su vida útil y el correcto funcionamiento de estos para reducir al máximo las posibles fallas que puedan intervenir en la calidad del producto final.
México cuenta con una autoridad nacional conocida como Comisión Federal para la Protección contra Riesgos Sanitarios (COFEPRIS), destacada por su capacidad técnica, operativa y regulatoria; la cual establece e implementa políticas, programas y proyectos en coordinación con organismos del sector público, privado y social con el fin de prevenir y atender los riesgos sanitarios, contribuyendo así a la salud de la población; de aquí la importancia de contar con la evidencia documentada de las pruebas realizadas previamente para demostrar que los equipos, sistemas críticos, instalaciones, personal y proveedores cumplen con los estándares establecidos por la NOM-059-SSA1-2015 para así validar los procesos ante cualquier auditoría.
Operación que bajo condiciones especificadas establece, en una
primera etapa, una relación entre los valores y sus incertidumbres de
medida asociadas obtenidas a partir de los patrones de medida, y las
correspondientes indicaciones con sus incertidumbres asociadas y, en
una segunda etapa, utiliza esta información para establecer una
relación que permita obtener un resultado de medida a partir de una
indicación.
Conviene no confundir la calibración con el ajuste de un sistema de
medida, a menudo llamado incorrectamente “autocalibración”, ni con
una verificación de la calibración.